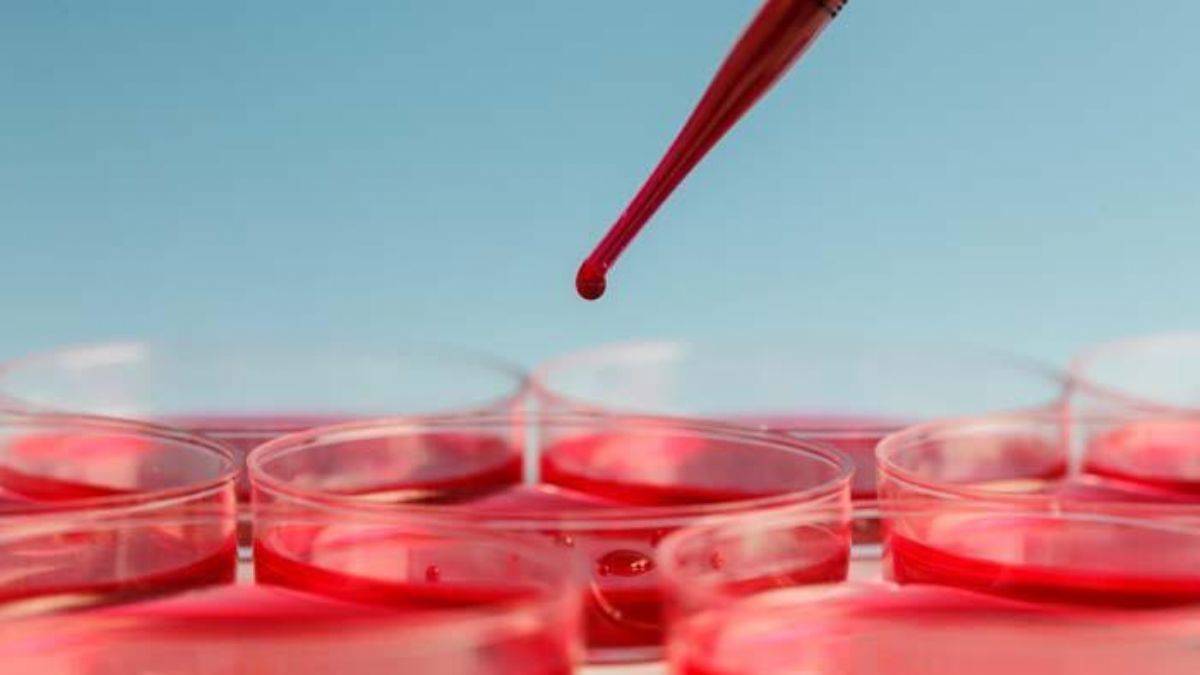
Kansızlığın 5 önemli nedeni ve vücuttaki 5 kritik belirtisi!

Kan sayımındaki düşüklüğün sebeplerinden biri kan kaybıdır. Bu ani görülen abondan dediğimiz fazla kanamalarla olabildiği gibi ufak ufak hissettirmeden olan kronik kanamalarla da meydana gelebilir. Ani gelişen hızlı ve bol miktardaki kan kayıplarının sebep olduğu klinik tablo biraz gürültülüdür. Genel durum bozukluğuyla beraber hastaneye acil müracaat gerektirir. Kayıp olan kan miktarını kan transfüzyonu ile acil yerine koymak gerekebilir.





Kronik böbrek hastalıkları, kanser hastalığı, AIDS hastalığı, hipotiroidi, kronik otoimmün hastalıklar, vücutta kırmızı kan hücre üretimini yavaşlatan kronik hastalıklardır.
Lenfoma, lösemi, multipl myelom gibi kan ile ilgili kanserler de kansızlık nedenidir. Akdeniz anemisi, orak hücreli anemi gibi kan hastalıkları da kansızlığa yol açar ve genetiktir. Bu nedenle kansızlık doğuştan itibaren görülür.

Yorum Yap